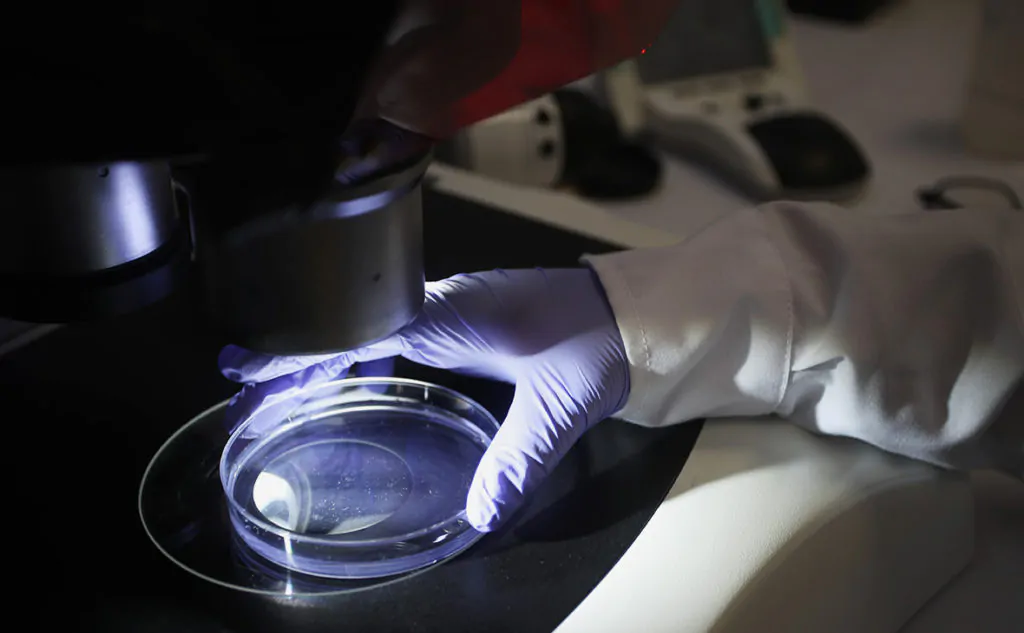

Для чего человеку знать свой ВИЧ-статус?
Ответ очевиден!
- При не выявленной ВИЧ-инфекции – продолжительность жизни 9-11 лет.
- Постановка диагноза СПИД при отсутствии лечения – 6-9 месяцев.
- При выявлении ВИЧ-инфекции на поздних стадиях и последующем лечении – 10-40 лет.
- Ранняя диагностика и эффективная ВААРТ – 20-50 лет.
Информирован – значит вооружен! Чем раньше произойдет выявление инфицирования, тем лучше. Пациенты с ВИЧ-инфекцией проходят высокоактивную антиретровирусную терапию, живут полноценной жизнью и доживают до глубокой старости. Определив свой ВИЧ-статус, вы проявляете заботу о своем здоровье и безопасности окружающих.
Синдром приобретенного иммунодефицита (СПИД)
СПИД – это сокращение от английского названия AIDS или «Синдром приобретенного иммунодефицита», что означает приобретенное отсутствие иммунитета.
- A – приобретенный, так как заболевание возникает у человека после заражения ВИЧ, то есть приобретается в течение жизни, а не передаётся по наследству (генетически).
- I – иммунный, так как влияет на иммунную систему, то есть на специализированные клетки, находящиеся в крови и борющиеся с различными инородными телами и микроорганизмами (бактериями, грибами, вирусами).
- D – дефицит, так как возникает слабость иммунной системы, и защитные силы теряют способность эффективно бороться с различными инородными телами и микроорганизмами.
- S – синдром, так как обозначает набор состояний и признаков заболевания, характерных для конкретного заболевания; больной СПИДом может страдать от целого ряда различных заболеваний и оппортунистических инфекций.
СПИД представляет собой последнюю и наиболее тяжелую стадию ВИЧ-инфекции, вызванную серьезным повреждением иммунной системы. СПИД – это фактически название группы заболеваний, возникающие в результате ослабленной иммунной системы человека, инфицированного ВИЧ.
Многочисленные микроорганизмы окружающие людей постоянно, но иммунная система здорового человека справляется с ними без видимых симптомов. У больных СПИДом обычные микроорганизмы приводят к широкому спектру воспалительных заболеваний. И пациент, в конечном итоге умирает, от инфекций, вызванных бактериями, вирусами, грибами, простейшими, не представляющих значительной опасности для здоровья людей.
ВИЧ также напрямую повреждает клетки нервной системы, вызывая тяжелые неврологические заболевания (ВИЧ-энцефалопатию).
Человек, инфицированный ВИЧ, не обязательно болен СПИДом.
Течение ВИЧ-инфекции
ВИЧ-инфекция протекает хронически. Начинается она с попадания вируса в кровоток и длится всю жизнь. Инфекция проникает в организм через слизистые оболочки или при прямом поступлении через кровь, атакует конкретную клетку иммунной системы – Т-лимфоцит.
Когда внутри Т-лимфоцитов образуется большое количество новых вирусов, они лопаются, выделяют множество вирусов в кровоток и распадаются. Вирусы попадают в новые Т-лимфоциты, и процесс повторяется. Таким образом, ВИЧ постепенно разрушает Т-лимфоциты, что приводит к ослаблению иммунитета и возникновению оппортунистических инфекций и некоторых злокачественных заболеваний.
Хотя ВИЧ в первую очередь атакует определенные клетки иммунной системы, Т-лимфоциты, он также может напрямую повредить некоторые другие клетки организма, например, нервные клетки, клетки слизистой оболочки пищеварительного тракта.
Прогрессирование ВИЧ-инфекции делится на 3 этапа:
- Острая ВИЧ-инфекция
Развивается через 3-6 недель после заражения. Чаще всего проявляется легким вирусным заболеванием (лихорадка, головная боль, боль в горле, боли в мышцах и суставах, сыпь, увеличение лимфатических узлов) и остается незамеченным. Обычно это длится от 1 до 3 недель.
Во время этой фазы в кровотоке циркулирует большое количество вируса, и человек очень заразен. ВИЧ в больших количествах присутствует в половом секрете. Вирус активно размножается, атакует и убивает клетки иммунной системы, что лучше всего видно по уменьшению количества лимфоцитов CD4.
- Бессимптомная ВИЧ-инфекция
Очень часто у ВИЧ-положительных людей отсутствуют какие-либо симптомы поражения иммунной системы. Это не показатель того, что иммунная система не повреждена.
Уровень вируса в крови может упасть очень низко, но человек до сих пор заражен и антитела могут быть обнаружены в крови. Недавние исследования показали, что на этой стадии ВИЧ не отдыхает, а очень активен в лимфатических узлах.
Большое количество клеток CD4 инфицируется и умирает, производя большое количество вируса. Эти факторы могут быть подтверждены путем измерения уровня клеток CD4 и количества вируса в крови. Длится от 7 до 10 лет .
- Симптоматическое заболевание ВИЧ (СПИД)
Имеет три фазы:
а) Ранняя — количество лимфоцитов CD4 резко падает, пока не достигнет 200, когда он переходит во вторую фазу.
Проявляется такими общими симптомами, как:
- лихорадка и потливость;
- потеря аппетита и массы тела – более 4,5 кг за 2 месяца;
- сильная утомляемость – продолжающаяся несколько недель без видимых причин;
- длительный понос;
- увеличение лимфатических узлов, особенно на шее и подмышках;
- грибковые инфекции ротовой полости;
- одышка и сухой кашель;
- розовые или пурпурные пятна на коже, обычно твердые и напоминающие синяки.
б) Продвинутая — количество лимфоцитов CD4 менее 200 , наблюдается развитие и поддержание этих общих симптомов с развитием характерных оппортунистических инфекций, заболеваний, опухолей, синдрома распада и деменции.
в) Поздняя — количество лимфоцитов CD4 менее 50 / мл. Эта стадия заболевания опасна для жизни, у нелеченных пациентов приводит к смерти.
Важно помнить, что вирус ВИЧ может передаваться от инфицированного человека не инфицированному на любой стадии инфекции
COVID-19
Семейство коронавирусов известно науке с середины XX века, когда был выделен первый штамм. До начала нового тысячелетия коронавирусы не причиняли человечеству особых беспокойств. Проблемы появились в 2002 году, когда в китайской провинции Гуандун началась эпидемия атипичной пневмонии, спровоцированная штаммом SARS-CoV. Следующим неприятным сюрпризом стал ближневосточный респираторный синдром в 2015 году, вызванный штаммом MERS-CoV. В декабре 2019 года в Ухане (Китай) была зарегистрирована вспышка коронавирусной инфекции, возбудителем которой стал неизвестный до этого штамм SARS-CoV-2. Чрезвычайно высокая контагиозность (заразность) нового вируса позволила ему в считанные месяцы распространиться по всей планете. В марте 2020 года ВОЗ объявила коронавирусную инфекцию пандемией «Ковид-19».
Пути передачи SARS-CoV-2
Коронавирус относится к респираторным вирусам, поэтому пути передачи идентичны любой ОРВИ. Разница — в высокой контагиозности, из-за чего риск инфицирования возрастает в сотни раз.
Заразиться можно двумя способами:
- Аэрогенным (воздушно-капельным). Мельчайшие частички (вирионы) вырываются изо рта и носа больного человека при кашле, чихании. При близком общении люди, игнорирующие средства защиты, просто вдыхают зараженный воздух.
- Контактно-бытовым. Вирус можно «поймать» через рукопожатие или через зараженную поверхность. Благоприятная среда для коронавируса на поверхностях — температура от 4 до -8,7℃ и атмосферная влажность 40-60%.
Алиментарный путь заражения признан крайне редким, но не исключен полностью. Не зарегистрированы и такие пути распространения инфекции, как гемоконтактный (через кровь), трансплацентарный (внутриутробный), трансмиссионный (через укусы кровососущих насекомых).
Клинические формы
С момента заражения до появления первых признаков болезни проходит от 2 до 14 дней. Средний интервал — 5 дней. Во время инкубационного периода у человека не обнаруживаются симптомы, но он является носителем вируса. Заболеванию подвержены все без исключения, тяжелые формы характерны для людей с отягощенным преморбидным фоном (сахарный диабет, сердечно-сосудистые патологии).
Клиническое течение болезни:
- Бессимптомное. О перенесенной инфекции человек, как правило, узнает по итогам анализа на антитела к коронавирусу.
- Легкое, в форме ОРВИ. Чаще болеют дети и люди без хронических заболеваний в анамнезе. Терапия проводится на дому с обязательным соблюдением самоизоляции.
- Среднетяжелое. Характеризуется коронавирусной пневмонией без дыхательной недостаточности. В большинстве случаев разрешается амбулаторное лечение под контролем врача.
- Тяжелое. На фоне пневмонии развивается острая дыхательная недостаточность (ОДН). Пациент нуждается в экстренной госпитализации.
Крайне тяжелой формой является развитие острого респираторного дистресс-синдрома (ОРДС), сопряженного с внесердечным отеком легких и гипоксией.
Симптомы, свидетельствующие о выздоровлении
О том, что болезнь отступает, можно понять по общему улучшению самочувствия. Сначала нормализуются показатели температуры. Стабильно нормальные значения держатся три дня и более.
Другие признаки выздоровления:
- Облегчение дыхания. При этом кашель и одышка могут сохраняться еще 7-10 дней.
- Исчезновение тошноты, головной боли, головокружений, першения в горле.
- Нормализация частоты сердечных сокращений, показателей сатурации.
- Прилив сил. Отступает слабость, становится легче двигаться, появляется возможность дольше находиться в вертикальном положении.
- Возвращение аппетита, обоняния.
Разница по длительности инкубационного периода
Инкубационный период – это период времени с момента попадания вируса в организм и до проявления его симптомов. Сколько же может длиться инкубационный период ОРВИ? На этот вопрос ответить тяжело. Все зависит:
- От вида вируса. Так, инкубационный период риновируса – от 1 до 5 дней, аденовируса – от 2 до 14 дней, вирусов гриппа – от 1 до 5 дней. Какие препараты при орз и простуде самые эффективные, указано здесь
- От иммунитета человека. Если иммунитет сильный, то человек даже при попадании в организм вируса не заболеет, а только будет его носителем в инкубационный период. Если иммунитет слабый, то заболеть можно в течении нескольких часов после заражения.
В среднем инкубационный период при ОРВИ может длиться от 2 часов до 5 дней. Вирус проявит себя в случае понижения иммунитета в этот промежуток времени.
На видео – длительность инкубационного периода орви:
Инкубационный период бактериальных инфекций более длительный, чем большинства вирусных: от 2 до 14 дней. Некоторые бактерии (например, менингококки, стрептококки, хламидии и др.) могут в дыхательных путях обитать годами, ничем не выдавая себя. А при стрессах или переохлаждении они активизируются. Отчет начала инкубационного периода начинается с момента переохлаждения, стресса, переутомления.
Возможно вас также сможет заинтересовать информация о том, как происходит лечение орз
Поставить правильный диагноз респираторных недугов в самом начале бывает сложно. При первых же симптомах заболевания нужно ограничить контакт с другими людьми, обратиться к врачу и выполнять все его рекомендации.
Запущенные стадии респираторных болезней грозят осложнениями с госпитализацией и лечением в стационаре. Не допускайте осложнений!
Профилактика коронавирусной инфекции
Специфическая профилактика коронавирусной инфекции
В настоящее время средства специфической профилактики коронавирусной инфекции находятся в стадии разработки.
Неспецифическая профилактика коронавирусной инфекции
Неспецифическая профилактика представляет собой мероприятия, направленные на предотвращения распространения инфекции, и проводится в отношении источника инфекции (больной человек), механизма передачи возбудителя инфекции, а также потенциально восприимчивого контингента (защита лиц, находящихся и/или находившихся в контакте с больным).
Мероприятия, направленные на восприимчивый контингент:
- Элиминационная терапия, представляющая собой орошение слизистой оболочки полости носа изотоническим раствором хлорида натрия, обеспечивает снижение числа как вирусных, так бактериальных возбудителей инфекционных заболеваний и может быть рекомендована для неспецифической профилактики.
- Не прикасаться к лицу, глазам не вымытыми руками. При отсутствии доступа к воде и мылу, для очистки рук использовать дезинфицирующие средства (одноразовая салфетка на спиртовой основе).
- Не прикасаться голыми руками к дверным ручкам, перилам, другим предметам и поверхностям в общественных пространствах.
- Избегать близких контактов и пребывания в одном помещении с людьми, имеющими видимые признаки ОРВИ (кашель, чихание, выделения из носа).
- Ограничить приветственные рукопожатия, поцелуи и объятия.
- Своевременное обращение в лечебные учреждения за медицинской помощью в случае появления симптомов острой респираторной инфекции является одним из ключевых факторов профилактики осложнений.
Медицинские маски для защиты органов дыхания используют:
- при посещении мест массового скопления людей, поездках в общественном транспорте в период роста заболеваемости острыми респираторными вирусными инфекциями;
- при уходе за больными острыми респираторными вирусными инфекциями;
- при общении с лицами с признаками острой респираторной вирусной инфекции.
Правила использования защитных масок
Маски могут иметь разную конструкцию. Они могут быть одноразовыми или могут применяться многократно. Есть маски, которые служат 2, 4, 6 часов. Стоимость этих масок различная, из-за различной пропитки. Какой стороной внутрь носить медицинскую маску – непринципиально. Маска уместна, если вы находитесь в месте массового скопления людей, в общественном транспорте, а также при уходе за больным, но она нецелесообразна на открытом воздухе. Во время пребывания на улице полезно дышать свежим воздухом и маску надевать не стоит.

Чтобы обезопасить себя от заражения, крайне важно правильно ее носить:
- маска должна тщательно закрепляться, плотно закрывать рот и нос, не оставляя зазоров;
- старайтесь не касаться поверхностей маски при ее снятии, если вы ее коснулись, тщательно вымойте руки с мылом или спиртовым средством;
- влажную или отсыревшую маску следует сменить на новую, сухую;
- не используйте вторично одноразовую маску;
- использованную одноразовую маску следует немедленно выбросить в отходы.
При уходе за больным, после окончания контакта с заболевшим, маску следует немедленно снять. После снятия маски необходимо незамедлительно и тщательно вымыть руки.
Российским гражданам, выезжающим в КНР, необходимо соблюдать меры предосторожности:
- при планировании зарубежных поездок уточнять эпидемическую ситуацию;
- не посещать рынки, где продаются животные, морепродукты;
- употреблять только термически обработанную пищу, бутилированную воду;
- не посещать зоопарки, культурно-массовые мероприятия с привлечением животных;
- использовать средства защиты органов дыхания (маски);
- мыть руки после посещения мест массового скопления людей и перед приемом пищи;
- при первых признаках заболевания, обращаться за медицинской помощью в лечебные организации, не допускать самолечения;
- при обращении за медицинской помощью на территории Российской Федерации информировать медицинский персонал о времени и месте пребывания в КНР.
Профилактика острых респираторных инфекций
Действительно эффективных мер по специфической профилактике ОРВИ пока не существует. Рекомендуется строгое соблюдение санитарно-гигиенического режима в зоне вспышки, включающего:
- регулярную влажную уборку и проветривание помещений;
- тщательное мытье посуды и средств личной гигиены;
- ношение ватно-марлевых повязок;
- частое мытье рук и т.д.
Чтобы повысить устойчивость детей к вирусу, их нужно закаливать. Возможен прием иммуномодуляторов. Также эффективный метод профилактики — вакцинация против гриппа.
Во время эпидемии необходимо избегать мест скопления людей, чаще гулять на свежем воздухе, принимать поливитаминные комплексы или препараты аскорбиновой кислоты. Рекомендуется в домашних условиях есть лук и чеснок каждый день.
Симптомы ОРВИ и гриппа
Мир вирусов очень богат и разнообразен, и, несмотря на общие проявления симптомов, существуют еще некоторые различия по клиническим признакам. Именно эти особенности помогают врачу более точно определить возможного возбудителя. Разберем часто встречающиеся вирусы:
- Аденовирусная инфекция
- Риновирусы
- Респираторно-синцитиальная инфекция
- Энтеровирусная инфекция
- Коронавирусная инфекция
Аденовирусная инфекция
Острое инфекционное заболевание, поражающее слизистые оболочки дыхательных путей, органов зрения, кишечника, лимфоидной ткани. Чаще заболевают дети и лица молодого возраста. Инкубационный период длится до 14 дней.
Основные симптомы:
- ринит (насморк) с обильным слизистым или водянистым отделяемым
- фарингит или тонзиллит
- конъюнктивит
- повышение температуры 37-38 °C и выше
Возможны проявления ларингита, трахеита, бронхита, увеличение нескольких групп лимфатических узлов, увеличение селезенки и печени. У детей возможна диарея, боли в животе.
Риновирусы
Острое, очень заразное инфекционное заболевание. Основным и ведущим симптомом является насморк (ринит) с очень обильными водянистыми выделениями.
Основные симптомы:
- выраженный ринит
- сухой кашель
- возможно развитие синусита и отита
- иногда повышение температуры до 37 °C и чуть выше
У маленьких детей болезнь протекает тяжелее, чем у взрослых. Но осложнения наблюдаются редко.
Респираторно-синцитиальная инфекция
Заболевание, которое характеризуется лихорадкой и развитием бронхита. Чаще болеют дети, особенно до 2 лет. Инкубационный период длится от 3 до 6 суток.
Основные симптомы:
- постоянный приступообразный сухой кашель, влажный кашель
- повышение температуры до 37-38 °C и выше
- чихание
- фарингит (редко)
Энтеровирусная инфекция
Это группа острых инфекционных болезней, вызываемых кишечными вирусами и характеризующаяся разнообразием вариантов клинического течения. Чаще всего болеют дети. Инкубационный период длится от 1 до 10 дней.
Основные симптомы:
- внезапный подъем температуры до 38-40 °С
- головная боль, общее недомогание, головокружение, слабость
- тошнота и рвота
- явления тонзиллофарингита в начале заболевания с проявлением сыпи в виде множественные красных пузырьков на дужках, мягком небе
- ринит
- сухой или влажный кашель
- часто сочетается с другими синдромами – кишечными расстройствами, болью в мышцах
Коронавирусная инфекция
Это группа инфекционных заболеваний, в большинстве случаев проявляется ринитом с обильными водянистыми выделениями из носа при отсутствии симптомов интоксикации и лихорадки, но с поражением нижних дыхательных путей. Инкубационный период составляет 1-14 дней.
Основные симптомы
Легкое течение:
- ринит
- повышение температуры до 37-38 °С
- головная боль, головокружение
- боль в мышцах и суставах
- боль в глазных яблоках
Осложненное течение:
- повышение температуры выше 38 °С
- сухой кашель
- одышка
- чувство нехватки воздуха
- головная боль, головокружение
- боль в мышцах и суставах
- боль в глазных яблоках
Возможны кишечные проявление в виде боли в животе, вздутия, диареи.
У большинства больных (80-90%) заболевание заканчивается выздоровлением.
Лечение вируса Эпштейн-Барр

Говоря о лечении ВЭБ-инфекции у взрослых, вернее, о лечении органной патологии, достоверно связанной с ВЭБ, или общего симптомокомплекса, обусловленного активной ВЭБ-инфекцией, или об упреждающей терапии высокоактивной ВЭБ-инфекции с целью предотвращения поражения органов и систем, следует сказать, что применение «препаратов интерферона в ректальных свечах или таблетках», «индукторов интерферонов», «иммуномодуляторов», а также БАДов, лазеротерапии, озонотерапии, плазмофереза, аутогемотерапии, системной энзимотерапии, гомеопатических средств, УФО крови, аппаратных методик для лечения вирусных инфекций и, в частности ВЭБ-инфекции, абсолютно не обосновано и не эффективно.
Механизм действия данных «препаратов» и методик, их воздействие на иммунную систему изучены поверхностно, «иммуномодулирующий» эффект описан лишь в общих чертах и не имеет доказательной базы. Не определены оптимальные показания для назначения «препаратов» и продолжительность их использования. Достоверное обоснование суточных и курсовых доз отсутствует.
В ряде исследований (в том числе, двойных слепых плацебо-контролируемых) продемонстрирована эффективность иммуноглобулинов для в/в введения у больных с герпесвирусными инфекциями, в том числе с ЭБВ-инфекционным мононуклеозом, а также альфа-интерферонов, рекомбинантных альфа-2а или альфа-2b-интерферонов при герпесвирусных инфекциях (генитальном и орофациальном герпесе, опоясывающим лишае) и бета-интерферонов при рассеянном склерозе с ремиттирующим течением, но, необходимы дальнейшие многоцентровые исследования, подтверждающие полученные данные.
Многие врачи, сталкиваясь с ИМ, считают, что это стрептококковая «ангина» и сразу назначают антибиотики. Иногда антибиотики назначаются «на всякий случай» — врача смущает увеличение миндалин, высокая температура тела и увеличение лимфатических узлов. Считается, что в среднем 9 из 10 врачей рекомендуют больным ИМ не нужную им антибактериальную терапию. На самом деле необоснованное назначение антибиотиков не улучшает, а ухудшает течение мононуклеоза, снижая показатели иммунитета, провоцирует появление пятнисто-папулезной сыпи и может вызвать различные побочные реакции.
Для лечения герпесвирусных заболеваний существуют препараты с прямым противовирусным действием:
- Ацикловир;
- Валацикловир;
- Фамцикловир;
- Фоскарнет при герпетических инфекциях;
- Бривудин для терапии опоясывающего лишая;
- Фоскарнет и Прителивир (в стадии апробации) для лечения больных с резистентностью к ацикловиру;
- Ганцикловир, Валганцикловир, Фоскарнет для лечения ЦМВ-инфекции;
- Препарат Цидофовир используют как для терапии ЦМВ-инфекции, так и в ряде исследований — для лечения инфекций, вызванных ВГЧ 6 и 7 типов.
Рандомизированных и контролируемых исследований по оценке эффективности безопасности перечисленных препаратов для лечения активной или манифестной ВЭБ-инфекции проведено не было. Дозировки препаратов и длительность курса подбираются индивидуально в зависимости от клинических проявлений, тяжести заболевания наличия иммуносупрессии и других факторов.
Противовирусную терапию у больных первичной лимфомой головного мозга (помимо АРТ при ВИЧ-инфекции), лимфомой Беркитта, назофарингеальной карциномой, другими типами лимфом или иных заболеваний, развитие которых связано с ВЭБ, на сегодняшний день не рекомендуют.
Вопросов о роли ВЭБ в той или иной патологии, диагностических и лечебных подходах в отношении ВЭБ-инфекции еще остается очень много. Только серьезные молекулярно-биологические, генетические и клинические исследования, которые вполне могут быть проведены и в нашей стране, дадут нам ответы. Но, и сейчас в своей клинической практике при обращении человека с возможной инфекцией, вызванной вирусом Эпштейна-Барр, мы должны действовать обоснованно, согласуясь с принципами доказательной медицины и, вместе с тем, максимально активно, когда мы уверены в своем диагнозе.
Все авторские права должны быть соблюдены.
Другие статьи по теме:
- Головная боль при коронавирусе
- Головные боли после коронавируса
- Головная боль после прививки от коронавируса
*Материалы, размещенные на данной странице, носят информационный характер и предназначены для образовательных целей. Посетители сайта не должны использовать их в качестве медицинских рекомендаций. Определение диагноза и выбор методики лечения остается исключительной прерогативой вашего лечащего врача! Клинический Институт Мозга не несёт ответственности за возможные негативные последствия, возникшие в результате использования информации, размещенной на сайте neuro-ural.ru.
Отличие вирусной инфекции от бактериальной
На протяжении жизни все мы неоднократно встречаемся с различными заболеваниями. Для того, чтобы их эффективно лечить, необходимо разобраться в том, какая инфекция стала причиной: вирусная или бактериальная.
Вирусами называют особый вид доклеточных организмов, паразитирующих на клетках живых организмов. Вследствие того, что сами вирусы не обладают собственным типом обмена веществ, они вынуждены паразитировать на живых клетках, используя питательные вещества, продуцируемые в ходе метаболизма клетки хозяина, тем самым разрушая её. По типу передачи вирусной инфекции можно выделить следующие пути заражения: воздушно-капельный, оральный, гематогенный (через кровь), алиментарный (через желудочно-кишечный тракт), контактный и половой. Попадая в организм человека, вирусы начинают активно размножаться, а кровь и лимфа способствуют их распространению. За короткое время инфекция разносится по всему организму.
Бактериальная инфекция
Бактерии – это одноклеточные организмы. В отличие от вирусов, они способны размножаться на различных искусственных питательных средах, что играет значимую роль при проставлении диагноза. Для бактериальной инфекции характерны так называемые «ворота» – путь, через который она попадает в организм. Как и в случае с вирусами, здесь так же присутствует множество способов передачи инфекции: контактный, алиментарный или воздушно – капельный, фекально-оральный. Бактерии могут попадать в организм через слизистые оболочки, с укусом насекомых (трансмиссивно) или животных. Попав в организм человека, они начинают активно размножаться, что и будет считаться началом бактериальной инфекции. Клинические проявления этого недуга развиваются в зависимости от локализации микроорганизма.

Сравнение
Для вирусной инфекции характерно общее поражение организма, в то время как бактериальная чаще всего действует локализовано. Инкубационный период при вирусной инфекции составляет от 1 до 5 дней, при бактериальном поражении – от 2 до 12 дней. Вирусная инфекция начинается «остро» с подъема температуры до 39 градусов и более. В этот момент наблюдается общая слабость и интоксикация всего организма. Бактериальная инфекция начинается исподволь с более выраженными симптомами и с температурой до 38 градусов. Иногда её появлению предшествует вирусная инфекция, в этом случае принято говорить о «второй волне» заболевания.
Выводы TheDifference.ru
- Вирусная инфекция поражает весь организм, бактериальная локализуется в одном месте.
- Вирусная инфекция начинается с подъёма температуры и общей интоксикации организма, бактериальный процесс развивается медленно, но характеризуется более выраженными клиническими симптомами.
- Для лечения вирусной инфекции используются противовирусные препараты, чтобы вылечить бактериальную инфекцию, потребуются антибиотики.
Этапы развития заболевания с учетом симптомов по дням
При легком течении инфекции и адекватной терапии выздоровление наступает на 14-15 день. Однако для нормализации состояния требуется еще двухнедельная реабилитация. Поэтому больничный лист с диагнозом, как правило, продлевают до одного месяца.
Поэтапное развитие COVID-19:
- 1 сутки — незначительное повышение температуры, появление слабости, першения в горле;
- 2-3 сутки — ухудшение состояния, гипертермия до 37,5-38℃, цефалгия, аносмия, сухой кашель, тошнота, головокружение;
- 4-5 сутки — болезненные ощущения в грудной клетке при кашле, ломота в мышцах, одышка, экстремальная слабость;
- 7-9 сутки — симптомы ослабевают, состояние стабилизируется.
С 10 дня пациенты постепенно идут на поправку. При неблагоприятном развитии событий появляются признаки коронавирусной пневмонии, а заболевание переходит в среднетяжелую форму.
Коронавирусная инфекция
Коронавирусы – это микроорганизмы, обладающие сферической формой и имеющие оболочку с небольшими шипами, напоминающую корону. Именно поэтому ученые дали название – коронавирус.

К семейству этого вируса относится более 40 видов и их количество постоянно увеличивается.
У людей острую респираторную инфекцию вызывают всего четыре вида коронавирусов.
Инфекция, вызываемая коронавирусом, распространена везде и возникает в течение всего года, однако большинство заболевших регистрируется все-таки зимой и ранней весной.
На долю коронаровирусной инфекции приходится до 20% всех случаев ОРВИ. Дети болеют в 5-7 раз чаще, чем взрослые.
Интересные факты
В XX веке коронавирусы были известны как возбудители острых респираторных заболеваний человека и животных.
Эти инфекции не относились к числу особо опасных вирусных инфекций и заканчивались выздоровлением.
Впервые коронавирус у человека был обнаружен в 1965 году у больных острой респираторной вирусной инфекцией.
Коронавирус длительное время не привлекал внимание ученых
Немного истории
В 2002—2003 годах в 33 странах была установлена вспышка атипичной пневмонии, возбудителем которой был признан коронавирус. Большинство заболевших было зарегистрировано в Китае и Сингапуре – 7761 человек, из которых 623 умерло.
В сентябре 2012 года на Ближнем Востоке были зарегистрированы случаи инфекции, вызванные коронавирусом. Заболевание протекало тяжело и смертность составила 43%. Эта форма инфекции получила название «Ближневосточный респираторный синдром».
В декабре 2019 года новая вспышка инфекции, вызванная коронавирусом, зарегистрирована в Китае.

Новый коронавирус относится к семейству Coronaviridae и отнесен ко II группе патогенности. Он предположительно является рекомбинантным вирусом между коронавирусом летучих мышей и неизвестным по происхождению коронавирусом.
В настоящее время данные по эпидемиологической характеристике новой коронавирусной инфекции ограничены.
Максимально широкое распространение вирус получил в Китае, где наблюдается распространение практически во всех провинциях с эпицентром в г. Ухань, провинция Хубэй.
Зарегистрированы завозные случаи в странах Азии, Северной Америки и Европы: Таиланд, Япония, Республика Корея, Вьетнам, Малайзия, Непал, Тайвань, Сингапур, Австралия, США, Канада, Франция, Германия.
Число стран с выявлением случаев инфекции выросло до 65-ти и с каждым днем увеличивается.
Первоначальный источник инфекции не установлен. Первые случаи заболевания связывают с посещением рынка морепродуктов в г. Ухань (КНР), на котором продавались домашняя птица, змеи, летучие мыши и другие животные.
Вирус неустойчив к действию различных неблагоприятных факторов, однако к нему имеется высокая восприимчивость человека независимо от возраста.
Вид вируса, вызвавшего «Ближневосточный респираторный синдром», является самым устойчивым и может сохраняться во внешней среде до 2-х суток.
Опасность вируса в современных условиях связана с тем, что он провоцирует быстрое развитие воспаления легких.
Основным источником инфекции является больной человек, в том числе находящийся в инкубационном периоде заболевания.
Пути передачи инфекции: воздушно-капельный (при кашле, чихании, разговоре), воздушно-пылевой и контактный.
Факторы передачи: воздух, пищевые продукты и различные предметы обихода.
Установлена возможность внутрибольничной передачи инфекции медицинскому персоналу, при оказании медицинской помощи.
Инкубационный период составляет от 2 до 14 суток и зависит от формы заболевания.
Патогенез новой коронавирусной инфекции изучен недостаточно.
Данные о длительности и напряженности иммунитета в настоящее время отсутствуют.
Иммунитет при инфекциях, вызванных другими представителями семейства коронавирусов, не стойкий и возможно повторное заражение.
Тяжесть и выраженность симптомов заболевания зависит от состояния иммунной системы человека: если организм ослаблен, то вероятность инфекционного поражения возрастает в несколько раз.
Симптомы гриппа
Вирус гриппа не зря выделяется большинством специалистов. Его отличия от обычных простуд: молниеносное развитие, повышенная тяжесть заболевания, необходимость комплексного лечения, повышенная смертность.
Грипп возникает неожиданно и в считанные часы полностью охватывает организм больного. Характерные симптомы гриппа:
- резкое повышение температуры (возможно повышение до 40,5);
- повышенная чувствительность к свету;
- боли во всем теле, головные и мышечные боли.
Наиболее активная фаза гриппа наступает на 3-5 день заболевания. Окончательное выздоровление возможно на 8-10 день.
Гриппозная инфекция поражает сосуды, поэтому у больных возможны десневые и носовые кровотечения.
Грипп
Грипп не является отдельным заболеванием, а входит в группу ОРВИ.
Грипп – это острое инфекционное заболевание, характеризующееся поражением верхних и нижних дыхательных путей (преимущественно трахеи). Проявляется высокой температурой, выраженными катаральными явлениями (кашлем, насморком, першением в горле и т.п.).
Его особое место среди ОРВИ обусловлено способностью вируса к постоянной антигенной изменчивости (мутации). Вирус гриппа очень активен и очень легко и быстро передается от больного человека к здоровому, особенно в местах большого скопления людей, включая общественный транспорт, школы, интернаты и детские сады.
По данным ВОЗ, каждый год в мире от 3 до 5 миллионов человек заболевают гриппом. К сожалению, в 250-500 тыс. случаев заболевание гриппом приводит к летальному исходу. Во время эпидемий гриппа активно болеют как взрослые, так и дети. Особенно уязвимыми являются люди старше 65 лет: среди этой группы населения больше всего распространены случаи смерти от гриппа. Эпидемии могут приводить к снижению производительности на предприятиях, чьи сотрудники отсутствуют на рабочих местах из-за болезни, а также ухудшению качества образования, так как школьники и студенты пропускают занятия. Во время эпидемий возрастает нагрузка на медицинские заведения, что влияет на качество медицинского обслуживания.
Грипп может протекать в легкой и среднетяжелой форме, которые заканчиваются полным выздоровлением. Но иногда развитие различных осложнений, наличие тяжелых хронический заболеваний сердца, сосудов, почек, легких могут привести к развитию тяжелой формы течения заболевания и у части больных – к летальному исходу.
Пациенты с онкологическими заболеваниями, пациенты с тяжелыми иммунными нарушениями и беременные наиболее подвержены высокому риску инфицирования из-за сниженного иммунитета.
Грипп передается воздушно-капельным путем, когда инфицирование происходит при разговоре, кашле и чихании, или контактно-бытовым путем, при котором частицы вируса оседают на бытовых предметах общего пользования (туалетная бумага, дверные ручки, посуда, детские игрушки).
Инкубационный период гриппа длится около 2 дней, но может варьироваться от 1 до 4 дней. Выделение вируса от больного человека при неосложненном течении гриппа продолжается 5-7 дней от начала заболевания, при осложненном – 10-14 дней. Высокая температура, сохраняющаяся более 5 дней, говорит о наличии бактериальных осложнений.





































